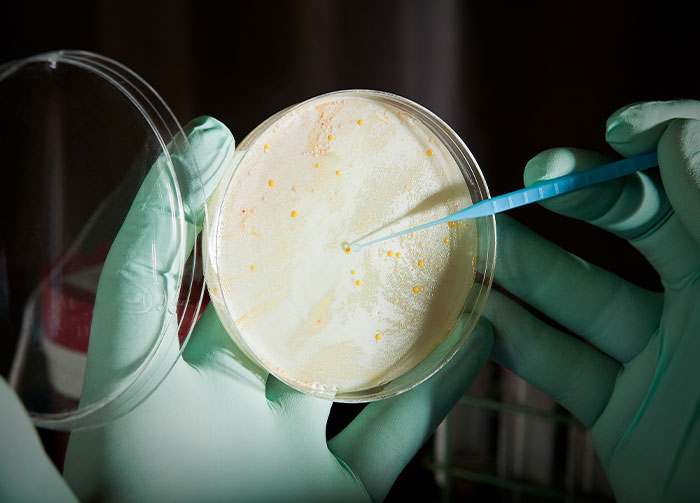
Some Things Only Exist Because People Are Dumb, Here Are 40 Of The Most Accurate Examples

Some Things Only Exist Because People Are Dumb, Here Are 40 Of The Most Accurate Examples
Interview With ExpertNo matter how weird it might sound, fear can actually be a positive thing. It helps guide our understanding of the world. It informs us about potentially dangerous situations and protects us from pain and long-lasting harm. However, some people’s metaphorical danger and common sense radars aren’t working like they should. Their survival instincts seem to be malfunctioning and lead to, frankly, reckless behavior.
In a thoroughly entertaining thread, the r/AskReddit community shared the things that exist only “because of people’s stupidity.” Do you know those warnings that you shouldn’t iron your clothes while still wearing them? That’s exactly the kinds of things they mean. We’ve collected some of the most bonkers examples to share with you. Scroll down, check them out, and upvote the most ludicrous ones.
Bored Panda wanted to figure out why some people seem to lack common sense and behave in risky ways, so we reached out to Glenn Geher, Ph.D., a professor of psychology at the State University of New York at New Paltz and a published author. He shed some light on our questions. You’ll find Dr. Geher’s insights as you read on.
This post may include affiliate links.
 Kardashians' Fame
Kardashians' Fame
Karda-who? And they're famous why? Oh. Famous nobodies who are famous for no reason...
“Much of the research in psychology speaks to individual differences in psychological traits. Some people have fantastic long-term memory but cannot find their keys to save their lives—whereas others are just the opposite,” Dr. Geher, from the State University of New York at New Paltz, told Bored Panda via email.
“Some things that seem like ‘common sense’ to one person might seem like trigonometry to the next. This diversity in people’s psychological traits is, to my mind, a beautiful thing. But it also helps to explain why some people just don’t understand certain things that seem obvious to others,” the psychology professor explained to us.
Dr. Geher pointed out to us that people’s survival instincts in the past were related to things that are very different from what we can find in the modern world.
 The anti-vax movement
The anti-vax movement
It shouldnt matter if soneone thinks vaccinations are dangerous. Its a public health concern. Them not being vaccinated could literally start another pandemic. What they 'believe' really shouldn't matter.
 All those drug commercials that tell you not to take said drug if you’re allergic to it.
All those drug commercials that tell you not to take said drug if you’re allergic to it.
“Furthermore, when it comes to things like reading directions or eating food with the wrapping on, we are partly talking about processes that only exist in the modern world and that did not exist during the lion’s share of human evolutionary history—so there is a mismatch there,” he said.
“I would posit that when it comes to ‘common sense’ for things that matched our ancestral conditions (e.g., staying away from venomous snakes), people, on average tend to do a bit better than when dealing with stimuli from the modern world. In a sense, what helps us to survive now (e.g., strapping in when driving) is very different from what would have helped our ancestors survive under ancestral conditions (e.g., avoiding snakes and cliff edges),” the professor told Bored Panda.
 The labels on superman costumes that say 'Wearing this does not enable you to fly'
The labels on superman costumes that say 'Wearing this does not enable you to fly'
 Influencers
Influencers
You mean the ones that take selfies with Large Wild Animals? Can't really hate those ppl since they're removing themselves from our gene pool
 The tag on the iron that says "Do not iron clothes while wearing them."
The tag on the iron that says "Do not iron clothes while wearing them."
How many of this exists because of people did self harm, just because they would sue the company for money?
We were also interested to find out how someone might go about cultivating a greater sense of awareness with regard to improving their survival instincts if they’re lacking. Dr. Geher was kind enough to walk us through this.
“On one hand, generally, the human brain can actually be pretty malleable—so some of these things may be learnable. On the other hand, some things are just very difficult for some people to learn,” the psychology expert noted that even if someone might want to master ballroom dancing, that might be next to impossible no matter how hard they try.
“I’d say that people can step back, be cognizant, and learn some basic ways to improve interfacing with—and surviving in—the modern world. But only to an extent,” Dr. Geher said.
“At the end of the day, the story of human psychology is a true mixture of fixed attributes and malleable attributes—we all have both.”
 In the user manual for RVs it specifies that the driver must remain in the drivers seat at all times when the RV is in motion because someone thought that cruise control was auto pilot and went to take a shower while on the freeway and crashed.
If I remember right, part of their argument against the company was that the manual did not say he had to remain in the drivers seat when cruise control was being used...
In the user manual for RVs it specifies that the driver must remain in the drivers seat at all times when the RV is in motion because someone thought that cruise control was auto pilot and went to take a shower while on the freeway and crashed.
If I remember right, part of their argument against the company was that the manual did not say he had to remain in the drivers seat when cruise control was being used...
I have to (want to) imagine they were high to think this. Like, that's just next level dumb. They thought the RV would navigate traffic with no indication other than "cruise control". It just seems crazy.
 Darwin Awards?
Darwin Awards?
The Darwin Awards are a tongue-in-cheek honor that originated in Usenet newsgroup discussions around 1985. They recognize individuals who have supposedly contributed to human evolution by selecting themselves out of the gene pool by dying or becoming sterilized via their own actions.
This is the epitome of something that exists because of stupid people. Should be at the top
Common sense isn’t as common as you might think. It seems absolutely obvious to (hopefully) all of you reading this that you should remove the plastic wrapper before eating something. Or that you shouldn’t use electric appliances in a bath.
However, not everyone is aware of simple things like this. Some individuals might have had very stressful or extremely sheltered upbringings, so they haven’t learned about the risks of doing certain things.
If they had a troubled childhood, they might not have had authority figures in their life teaching them these all-important lessons. Meanwhile, if they were being mollycoddled all the time, they might not have any hands-on experience doing basic chores like ironing, mowing the lawn, cooking, and cleaning. What’s common sense to you and yours truly (hi!) might be rocket science to someone else.
 Flat earth theory.
Flat earth theory.
flat earthers aren't actually that bad though because they are a group that is acceptable to make fun of.
 religion
religion
Religion isnt the problem , its the church or what ever your country calls it. You dont need a middle man (person) to have faith
 [This sign at the London Luton airport](https://imgur.com/WqYDff0)
[This sign at the London Luton airport](https://imgur.com/WqYDff0)
On the other hand, some individuals can have warped perceptions of danger and morality. They might not understand how risky it is to touch the spinning blades of a lawn mower, for instance, but they want to see what happens anyway.
Other people might take things far too literally. That means that unless something is expressly prohibited, they might not know to avoid doing it.
Similarly, they may have problems with understanding the consequences of their actions. They might focus only on short-term issues and rewards, completely ignoring the long-term.
 Traffic jams. Except for in outlying cases it's literally only bc people are too dumb to be efficient
Traffic jams. Except for in outlying cases it's literally only bc people are too dumb to be efficient
 The ban on Kinder eggs in the US.
Are people really stupid enough to swallow those eggs whole? Even if they didn't know about the toy, you can't possibly want to deepthroat a f*****g egg, can you?
The ban on Kinder eggs in the US.
Are people really stupid enough to swallow those eggs whole? Even if they didn't know about the toy, you can't possibly want to deepthroat a f*****g egg, can you?
It's not about people being stupid. It's about a regulation set out by the Food and Drug Administration in 1938. Essentially, the law dictates that any food with a ‘non-nutritive object embedded’ – including toys embedded inside confectionery items – is not allowed, ostensibly to prevent choking hazards, so it's actually a reasonably law. A special exception would need to be carved out for Kinder, and it's yet to happen.
 Do not open door in flight
Edit: Neat, an award stating how helpful my comment is. Thank you, glad to help
Do not open door in flight
Edit: Neat, an award stating how helpful my comment is. Thank you, glad to help
Oh look there's my house, you can let me out here. I'll just see myself out😆
However, at other times, fear dominates people’s lives. Instead of being a reaction to real threats, it rises up as a response to imagined dangers. If left unchecked, it can go out of control and cause a lot of unneeded stress.
If you’re feeling excessive, irrational fear and it’s disrupting your daily life, you may need to talk to a health professional. They’ll be able to figure out what’s going on. You might be dealing with some sort of anxiety disorder, have a serious medical condition, or may be dealing with a phobia. In the latter case, you may want to seek a mental health specialist’s help. They can help reframe your fears so that they’re no longer disrupting your day-to-day routine.
The important thing to remember is that these people are professionals. They've got plenty of experience. They won't judge you. It's not a weakness to ask for a helping hand or some advice when you need it.
Televangelists.
Ironically, televangelists are the only people who make me hope there is a God. Because when He gets a hold of them He is going to mess with them big time.
 Label on Swiss chainsaw, do not attempt to stop chain with hands and genitals
Label on Swiss chainsaw, do not attempt to stop chain with hands and genitals
Hands is stupid, but you can basically figure that out. I want to know the story on who tried to stop a chainsaw with their genitals.
 Panic buying
Panic buying
Meetings that could have been emails
 The law in Pennsylvania that *specifically* states that you can not barter infant children
The law in Pennsylvania that *specifically* states that you can not barter infant children
It doesn't exist because of stupid people. It exists because of desperate people. When times were so bad you had to sell one child so you could afford to feed the others.
 California's Prop 65.
It says everything sold in California must have a label warning consumers that the product is made with ingredients/components known by the state of California to cause birth defects or cancer. Unless the seller can prove that the item does not contain such components. However, nobody can actually say if anything causes cancer or not. So if you sell something in California, you must either pay a laboratory to test everything in your product, then provide reports stating that each element does not cause cancer. OR you can buy a 1 cent sticker and slap it on your packaging. As a result everything sold in California, EVERYTHING, has that sticker on it. Because why wouldn't you just slap the sticker on?
We voted for this.
California's Prop 65.
It says everything sold in California must have a label warning consumers that the product is made with ingredients/components known by the state of California to cause birth defects or cancer. Unless the seller can prove that the item does not contain such components. However, nobody can actually say if anything causes cancer or not. So if you sell something in California, you must either pay a laboratory to test everything in your product, then provide reports stating that each element does not cause cancer. OR you can buy a 1 cent sticker and slap it on your packaging. As a result everything sold in California, EVERYTHING, has that sticker on it. Because why wouldn't you just slap the sticker on?
We voted for this.
 The warning sticker on lawn mowers telling you not to touch the blades while they are in motion.
The warning sticker on lawn mowers telling you not to touch the blades while they are in motion.
 The Tide Pod challenge
The Tide Pod challenge
Forrest Gump? He does himself so many stupid things, but gets away with it. Here we say: "God protects the stupid."
Load More Replies...Had to google, in case there is one more person like me out there: Tide pods are laundry detergent
But what's the challenge? On the picture it looks like somebody is going to eat it! Are they really THAT stupid?
Load More Replies...Also that one where you bite the fluffy part of a cattail.
I have no idea what the tide pod challenge is but... do I even want to know?
Eating laundry detergent, humans are stupid.
Load More Replies...If anyone is that dumb maybe it is for the best...we always need to thin the herd.
I'm pretty sure there were very few cases of anyone actually doing it. For the most part it was a meme that got misinterpreted by news orgs as being more literal than it was
They taste great if you use a little splash of downy on them! /s (yeah gotta put that there!)
Our local CVS had tide and Gain pods on an end cap with candy bars. Tidepods-6...3b6852.jpg 
Solution to the problem- Cover it up with a nice shiny tinfoil wrapper, so you'll know your dying child is really resourceful!
You know, someone pointed out, in a news article I was reading, that this wasn't as "epidemic" as it was made out to be. Did it happen? Yes. Was it as huge as we were led to think? NOPE. Lesson from that: when the media (and Dr. Phil) get "screechy" about something, it's generally a molehill made to look like a mountain.
Why even make products in those pods? Just pour the stuff into the machine, folks!
Hey, I have an actual helpful answer to this! Because there are two (or more) ingredients in those pods, that react when they combine. You can't do that with stuff out of one bottle :)
Load More Replies...  “Warning may contain nuts” warnings on packets of nuts
“Warning may contain nuts” warnings on packets of nuts
The law requires this for all products that may contain nuts (to protect people from dying) so it would seem a bit odd for the law to state "unless it's obvious, then you don't need to state it may contain nuts". I think it's amusing but not evidence that people are stupid.
 I worked at Cabela's for years and they carry a product called "The Butt Out" and its a tool a hunter would use to remove the a**s from a deer. On the back of the packaging in the bottom corner is a warning stating "Not for sexual use"
I worked at Cabela's for years and they carry a product called "The Butt Out" and its a tool a hunter would use to remove the a**s from a deer. On the back of the packaging in the bottom corner is a warning stating "Not for sexual use"
Please someone tell me why you need to rip the a*****e out of a deer in the first place?!?!
 Warning labels telling you not to eat things that are not food.
Warning labels telling you not to eat things that are not food.
fun fact silica is not poisonous it tells you not to eat it as you could choke on it
The sticker on curling irons that say “for external use only”
well there was this girl who wrote kind of a bad review on her "new vibrating toy" that it was getting awfully hot when used, to the point where it burned her. Seemed kind of fair thing to complain about ...until you spotted the picture of said product and realised that it was a curling iron.
Bullying
Engaging in acts of hatred and violence against others for being different is a hallmark of low intelligence.
 https://imgur.com/gallery/F3apENt This was in front of a catholic school I did some work on. This is not the only tree in the area, it's not even the only tree in front of a parking space. How did this sign come to be? The world may never know
https://imgur.com/gallery/F3apENt This was in front of a catholic school I did some work on. This is not the only tree in the area, it's not even the only tree in front of a parking space. How did this sign come to be? The world may never know
 Warning labels on electric appliances warning you not to use them in a bathtub.
Warning labels on electric appliances warning you not to use them in a bathtub.
In France, a huge popstar from the 60´s who had OTC adjusted a lamp which was slightly tilted from his bathtub => we have strict rules for electrical safety in bathrooms.
 Most people
Most people
 The f*****g message on my in dash display on my Honda Fit.
YES I KNOW I AM RESPONSIBLE FOR THE OPERATION OF THIS MOTOR VEHICLE.
Imagine the car not telling me that every time I start it, me getting in an accident, and suing Honda for NOT telling me that I'm responsible for the car I'm driving?
The f*****g message on my in dash display on my Honda Fit.
YES I KNOW I AM RESPONSIBLE FOR THE OPERATION OF THIS MOTOR VEHICLE.
Imagine the car not telling me that every time I start it, me getting in an accident, and suing Honda for NOT telling me that I'm responsible for the car I'm driving?
""Possible ice on the road". My brother in christ, it's -15 Celsius and there's more than a meter of snow on the ground, I can see the ice on the road.
 The warning on strollers, "Do not collapse while infant is seated"
The warning on strollers, "Do not collapse while infant is seated"
The informal version should be "Do Not turn infant into a human pretzel" or "Your infant does not have the ability to become a rubber band ball."
The belief that brown cows give chocolate milk
 Fruit roll boxes that warn "Remove plastic wrap before eating"
Fruit roll boxes that warn "Remove plastic wrap before eating"
I never seen this before. If one is given to me, I might attempt to eat that rolled wrappers too. They look edible. Especially since there is already an outer wrapper protecting them.
There was a washing machine I saw in Thailand and it said please do not put children in here
Tabloid newspapers
Is this meant to be regarded as a contradiction? Like, how can a digital newspaper still be called a »paper«???
The debate of whether or not video games cause violence
Video games don't cause violence on their own. In some situations they can prevent real-life violence because they give an outlet for expressing that anger and rage in a controlled environment!
Measles
Loot boxes (for purchase) in video games, especially games that required initial purchase just to play them.
"Do not eat" label on silica gel packets. Like does it actually look like food to anyone?
my guess is that it could look like candy to small children, lets hope that they can read.
July and August having 31 days back to back like that extra day would've ended with February But some people just want to watch the world burn
Blame Julius Caesar and his grandson Augustus. They each wanted "their" month to have 31 days ..
The lottery
Finally! Gambling wouldn't exist if people weren't stupid. All forms of gambling. If the odds are against you, and you know they're against you, only a fool would be sucked in.
Toilet roll and hand sanitiser shortages.
OSHA
The Occupational Safety and Health Administration (OSHA) is about people being dumb. It's about corporations cutting corners such that it makes working conditions dangerous for their employees. Trust me, you want OSHA.
I liked the one on the box of a little trampoline I bought " Do not use in rooms with low ceilings"!
Recently i came across Jeep's owner's manual made for USA market. The sheer amount of warning labels on every page was astonishing - "open key fob away from your body, especially your eyes" , "an unlocked vehicle is an invitation to thieves" , "do not run engine in closed garage" , "do not leave keys in reach of children" , "cruise control cannot take street, traffic and weather conditions into account" - have people totally lost their ability to think?
Years ago I was looking for some piece of information in the manual for my Suzuki. It took me the longest time to find it, because it was in one of those bold black bordered WARNING! boxes that I long ago became conditioned to ignore because they always say things like "don't drink the battery acid" or "don't try to change the belts while the motor is running".
Load More Replies...I like the little allergy message on bags of nuts which say may contain nuts. Always makes me laugh.
The thing is, plenty of people ARE stupid. As in, have a low IQ or no common sense. And all of us are stupid under the right circumstances. Should people be electrocuted or mutilated just because they're stupid? Of course, warning labels may not be that helpful, but surely stupid people deserve some kind of protection?
Warning labels aren't protection. Warning labels are legal a**e-covering, like the "I have read the terms and conditions" check box. And the miniature disclaimer text on the bottom of TV advertisements.
Load More Replies...On a bottle of soda I bought from Japan..."Do not insert p-e-n-i-s in bottle opening". Yes, the warning was in English.
I’m just curious; have ANY of those examples been seen or of the US? Not (only) being willing to mock them, I understand that there are laws down there requesting (thanks to stupid people) such precise messages, but has it been needed in other places? Writing from Switzerland here; if you are not mentally disabled, a court would state that this all is common sense, I think…
TL;DR Watch "hot coffee" on youtube! The law in the US seems very funny, but its actually made with good intentions. (Speaking as a German with loads of overlap with product conpliance in my job). US companies can get sued to an amount appropriate to make them change their behavior (e.g. make them redesign an unsafe product) whereas in the EU there is much more upfront regulation, but tiny punishments (In Germany there used to be something called "Knochentabelle" that stated something like: lost finger, left hand = 800€. In the US the damage would be calculated in relation to the profit the product makes. Really: Watch a 10minute "hot coffee" documentary on youtube! Here is the catch: big corporations have jumped on the PR concept of ridiculing these laws to undermine them. Making it seem like they are made for greedy idiots who want to get rich by intentionally hurting themselves. Undermining the public outcry there should be for more responsibility of corporations.
Times: https://m.youtube.com/watch?v=pCkL9UlmCOE&pp=ygUSeW91dHViZSBob3QgY29mZmVl Or more "entertaining": https://m.youtube.com/watch?v=KNWh6Kw3ejQ
Load More Replies...Anyone ever noticed the "Do not insert into ear canal" warning on birthday candles?
"I'm not saying we should k¡ll all the stupid people. I'm just saying we remove all the warning labels and let Nature take its course." - source unknown
I liked the one on the box of a little trampoline I bought " Do not use in rooms with low ceilings"!
Recently i came across Jeep's owner's manual made for USA market. The sheer amount of warning labels on every page was astonishing - "open key fob away from your body, especially your eyes" , "an unlocked vehicle is an invitation to thieves" , "do not run engine in closed garage" , "do not leave keys in reach of children" , "cruise control cannot take street, traffic and weather conditions into account" - have people totally lost their ability to think?
Years ago I was looking for some piece of information in the manual for my Suzuki. It took me the longest time to find it, because it was in one of those bold black bordered WARNING! boxes that I long ago became conditioned to ignore because they always say things like "don't drink the battery acid" or "don't try to change the belts while the motor is running".
Load More Replies...I like the little allergy message on bags of nuts which say may contain nuts. Always makes me laugh.
The thing is, plenty of people ARE stupid. As in, have a low IQ or no common sense. And all of us are stupid under the right circumstances. Should people be electrocuted or mutilated just because they're stupid? Of course, warning labels may not be that helpful, but surely stupid people deserve some kind of protection?
Warning labels aren't protection. Warning labels are legal a**e-covering, like the "I have read the terms and conditions" check box. And the miniature disclaimer text on the bottom of TV advertisements.
Load More Replies...On a bottle of soda I bought from Japan..."Do not insert p-e-n-i-s in bottle opening". Yes, the warning was in English.
I’m just curious; have ANY of those examples been seen or of the US? Not (only) being willing to mock them, I understand that there are laws down there requesting (thanks to stupid people) such precise messages, but has it been needed in other places? Writing from Switzerland here; if you are not mentally disabled, a court would state that this all is common sense, I think…
TL;DR Watch "hot coffee" on youtube! The law in the US seems very funny, but its actually made with good intentions. (Speaking as a German with loads of overlap with product conpliance in my job). US companies can get sued to an amount appropriate to make them change their behavior (e.g. make them redesign an unsafe product) whereas in the EU there is much more upfront regulation, but tiny punishments (In Germany there used to be something called "Knochentabelle" that stated something like: lost finger, left hand = 800€. In the US the damage would be calculated in relation to the profit the product makes. Really: Watch a 10minute "hot coffee" documentary on youtube! Here is the catch: big corporations have jumped on the PR concept of ridiculing these laws to undermine them. Making it seem like they are made for greedy idiots who want to get rich by intentionally hurting themselves. Undermining the public outcry there should be for more responsibility of corporations.
Times: https://m.youtube.com/watch?v=pCkL9UlmCOE&pp=ygUSeW91dHViZSBob3QgY29mZmVl Or more "entertaining": https://m.youtube.com/watch?v=KNWh6Kw3ejQ
Load More Replies...Anyone ever noticed the "Do not insert into ear canal" warning on birthday candles?
"I'm not saying we should k¡ll all the stupid people. I'm just saying we remove all the warning labels and let Nature take its course." - source unknown

 Dark Mode
Dark Mode 

 No fees, cancel anytime
No fees, cancel anytime